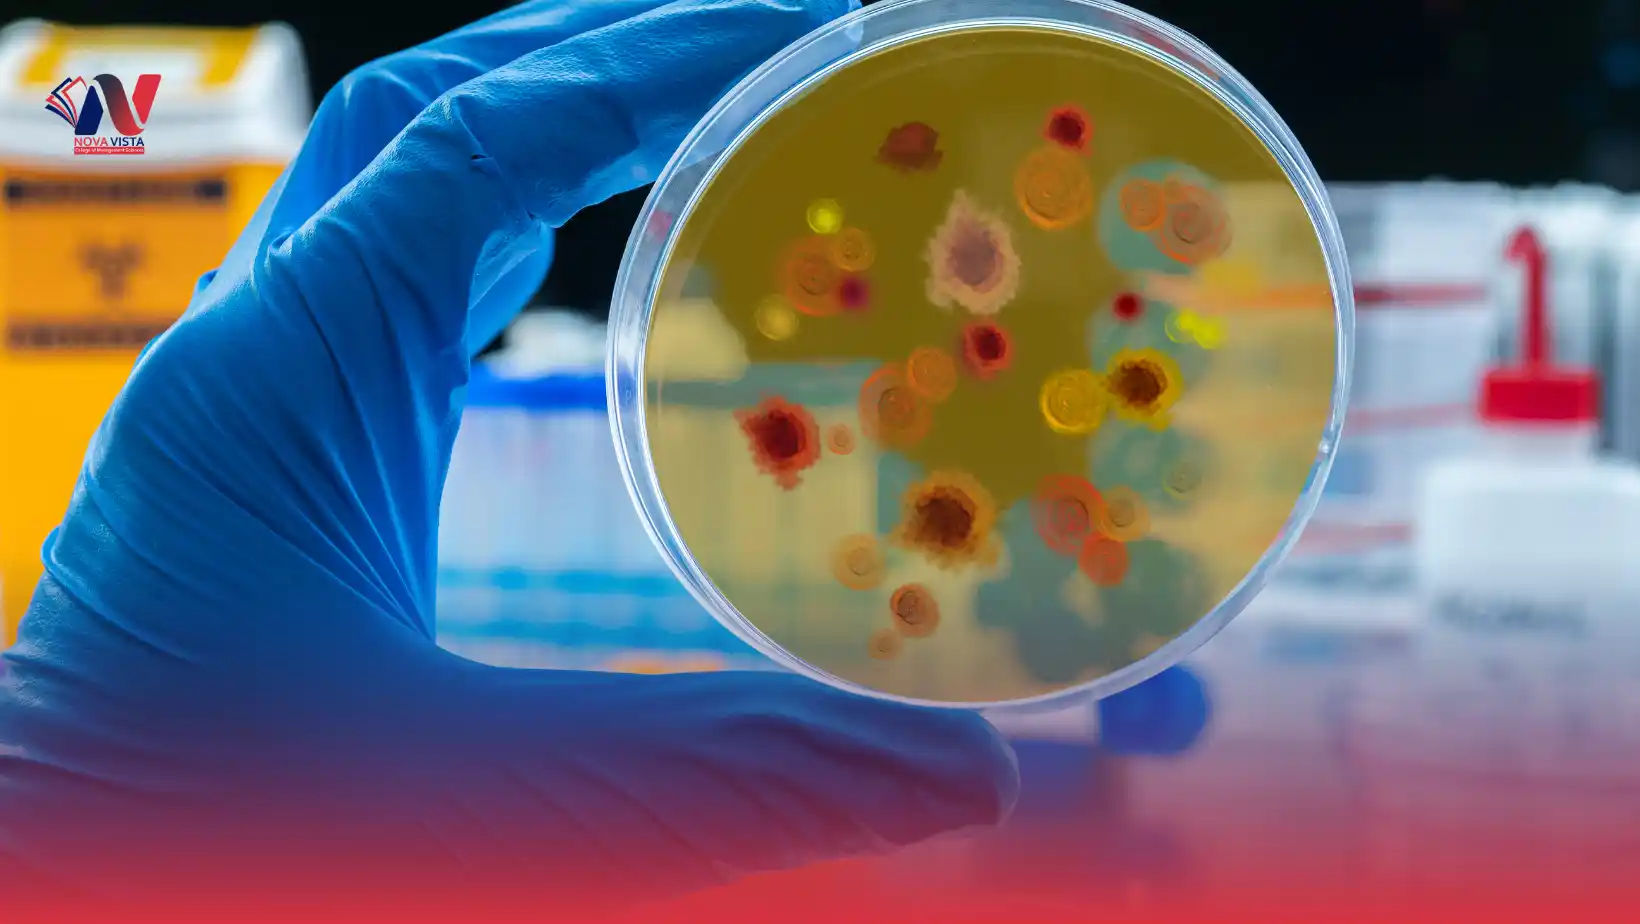
ICTQual AB Level 6 International Diploma in Public Health and Epidemiology

Take your career in healthcare and research to the next level with the ICTQual AB Level 6 International Diploma in Public Health and Epidemiology, a globally recognized qualification designed for aspiring public health professionals, researchers, and policymakers. This Level 6 Public Health and Epidemiology Diploma online equips learners with advanced knowledge and practical skills to analyze, manage, and improve population health on a local and global scale.
Whether you are a recent graduate, healthcare practitioner, or professional in a related field, this international diploma in Public Health and Epidemiology provides a comprehensive understanding of disease prevention, health policy, epidemiological research, and data-driven decision-making. Learners gain the advanced Public Health and Epidemiology certification needed to design public health programs, conduct epidemiological studies, and implement effective interventions that improve community health outcomes.
The ICTQual Level 6 Public Health and Epidemiology course blends theoretical knowledge with practical applications, covering epidemiological methods, biostatistics, health surveillance, outbreak investigation, health promotion, and global health strategies. Students develop the ability to interpret health data, assess population risks, and contribute to evidence-based public health planning.
With flexible online learning options, this course allows students to balance professional or personal commitments while earning an internationally recognized credential. By enrolling in this program, learners not only boost their career in public health and epidemiology but also enhance skills in research, leadership, and strategic health management.
Advance your expertise, gain global recognition, and make a meaningful impact on population health with the ICTQual AB Level 6 International Diploma in Public Health and Epidemiology—your gateway to a rewarding, internationally recognized career in public health, epidemiology, and healthcare leadership.
Awarding Body
ICTQual AB
Study Mode
Online
Qualification Level
Level 6
Completion Time
3-Years
Study Units
36 Mandatory Units
Assessments
Assignments & Evidences Based
| Qualification Title | ICTQual AB Level 6 International Diploma in Public Health and Epidemiology |
| Level | Level 6 |
| Total Credits | 360 |
| Assessment | Pass or fail Internally assessed and verified by centre staff External quality assurance by ICTQual AB verifiers |
To enrol in the ICTQual AB Level 6 International Diploma in Public Health and Epidemiology, applicants must meet the following entry criteria:
Minimum Age
- Applicants must be 18 years of age or older at the time of registration.
Educational Background
- Candidates should hold a Level 5 qualification in Public Health, Healthcare, Life Sciences, or related fields.
- Recent graduates in medicine, nursing, health sciences, or epidemiology are eligible for the Level 6 Public Health and Epidemiology Diploma online.
- A strong foundation in biology, statistics, and health research methods is recommended.
Work Experience
- Professionals with 2–6 years of verifiable experience in healthcare, public health, epidemiology, or research are encouraged to apply.
- Work experience enhances practical understanding of population health management, outbreak investigation, and health program implementation.
English Language Proficiency
- Since the course is delivered in English, learners must demonstrate good English communication skills (reading, writing, and speaking).
- Non-native English speakers may be asked to provide evidence of proficiency (e.g., IELTS, TOEFL, or equivalent).
Commitment to Continuing Professional Development (CPD)
- Candidates should be committed to ongoing Continuing Professional Development to apply advanced public health and epidemiology knowledge in professional settings.
- Participation in workshops, research, and evidence-based projects is essential for successful course completion.
Access to Required Resources
- Learners must have access to a computer or device with reliable internet for online learning.
- Access to statistical software, research databases, or public health tools is recommended for practical exercises.
- Familiarity with data analysis, reporting, and research methodologies supports learning and assessment.
This qualification, the ICTQual AB Level 6 International Diploma in Public Health and Epidemiology, consists of 36 mandatory units.
Mandatory Units of ICTQual AB Level 6 International Diploma in Public Health and Epidemiology
This qualification, the ICTQual AB Level 6 International Diploma in Public Health and Epidemiology 360 Credits – Three Years, consists of 36 mandatory units.
Year 1: Foundation in Public Health and Epidemiology
- Introduction to Public Health
- Fundamentals of Epidemiology
- Human Anatomy and Physiology for Public Health
- Biostatistics and Health Data Analysis
- Principles of Microbiology and Infection Control
- Health Promotion and Disease Prevention
- Nutrition and Community Health
- Environmental Health and Sustainability
- Health Policy and Systems Overview
- Communication Skills for Health Professionals
- Ethics and Professional Conduct in Public Health
- Introduction to Research Methods in Health Sciences
Year 2: Intermediate Public Health Applications
- Advanced Epidemiology and Study Design
- Infectious Disease Control and Prevention
- Non-Communicable Diseases and Chronic Care Management
- Global Health Issues and Health Systems
- Health Economics and Policy Implementation
- Public Health Surveillance and Monitoring
- Occupational and Environmental Health
- Community Health Assessment and Planning
- Health Informatics and Digital Health Systems
- Programme Evaluation and Impact Assessment
- Leadership and Teamwork in Public Health
- Applied Research Methods in Epidemiology
Year 3: Advanced Specialisation and Professional Application
- Advanced Public Health Interventions
- Clinical Epidemiology and Evidence-Based Practice
- Health Risk Assessment and Management
- Biostatistics for Advanced Research
- Global Health Policy and Strategy Development
- Emergency Preparedness and Disaster Management
- Maternal and Child Health Epidemiology
- Advanced Communicable Disease Control
- Health Communication and Advocacy
- Quality Improvement and Risk Management in Healthcare
- Capstone Research Project / Dissertation
- Professional Practice and Field Placement
Upon successful completion of the ICTQual AB Level 6 International Diploma in Public Health and Epidemiology, learners will be able to:
Year 1: Foundation in Public Health and Epidemiology
Introduction to Public Health
- Understand the core principles and scope of public health practice.
- Explore the role of public health in promoting community well-being.
- Identify key determinants of health and disease in populations.
- Apply public health concepts to real-world health challenges.
- Develop awareness of global health issues and interventions.
Fundamentals of Epidemiology
- Explain basic epidemiological concepts, measures, and study designs.
- Analyze disease patterns, incidence, and prevalence in populations.
- Apply epidemiological methods to investigate health outcomes.
- Interpret epidemiological data to inform public health decisions.
- Develop skills for planning and conducting population-based studies.
Human Anatomy and Physiology for Public Health
- Describe human body systems relevant to disease prevention and health promotion.
- Correlate physiological processes with public health interventions.
- Understand the impact of biological factors on population health.
- Apply anatomy and physiology knowledge to community health programs.
- Support evidence-based public health decision-making using biological insights.
Biostatistics and Health Data Analysis
- Apply statistical methods to analyze health and epidemiological data.
- Interpret research findings for population health assessment.
- Use statistical software for data analysis in public health studies.
- Understand probability, correlation, and regression in health research.
- Develop data-driven solutions for public health problems.
Principles of Microbiology and Infection Control
- Identify pathogenic microorganisms and their public health impact.
- Implement infection prevention and control strategies.
- Analyze microbial transmission in community and healthcare settings.
- Apply laboratory findings to public health planning.
- Develop knowledge of microbiology for outbreak management and disease prevention.
Health Promotion and Disease Prevention
- Design effective health promotion programs for diverse populations.
- Understand behavioral, social, and environmental determinants of health.
- Apply strategies to prevent communicable and non-communicable diseases.
- Develop evaluation plans to assess program effectiveness.
- Advocate for community health improvement initiatives.
Nutrition and Community Health
- Understand the role of nutrition in public health and disease prevention.
- Design community nutrition programs to address health challenges.
- Evaluate dietary patterns and their impact on population health.
- Promote healthy eating behaviors through education and policy.
- Integrate nutrition strategies into public health interventions.
Environmental Health and Sustainability
- Assess environmental determinants of health, including water, air, and sanitation.
- Analyze the impact of environmental hazards on population health.
- Develop sustainable strategies to reduce environmental risks.
- Apply policies and regulations to improve community environmental health.
- Promote awareness of climate change and its effects on health.
Health Policy and Systems Overview
- Understand health systems, structures, and service delivery models.
- Analyze health policy development and implementation.
- Evaluate the effectiveness of health programs and interventions.
- Apply knowledge of health governance to improve population outcomes.
- Develop strategies to strengthen health systems at local and global levels.
Communication Skills for Health Professionals
- Develop effective verbal and written communication skills.
- Communicate public health messages to diverse audiences.
- Present research findings clearly and persuasively.
- Collaborate effectively within multidisciplinary health teams.
- Use communication to influence health policy and behavior change.
Ethics and Professional Conduct in Public Health
- Apply ethical principles in public health practice and research.
- Understand patient rights, confidentiality, and informed consent.
- Analyze ethical dilemmas in population health and interventions.
- Promote professional integrity in healthcare and community settings.
- Integrate ethical decision-making into public health programs.
Introduction to Research Methods in Health Sciences
- Understand research design, methodology, and evidence-based practice.
- Conduct literature reviews and critical appraisal of studies.
- Collect, analyze, and interpret health research data.
- Develop foundational skills for conducting public health research.
- Apply research findings to inform population health strategies.
Year 2: Intermediate Public Health Applications
Advanced Epidemiology and Study Design
- Design and implement advanced epidemiological studies for population health.
- Analyze risk factors, disease patterns, and trends in communities.
- Apply statistical and research methods to evaluate public health data.
- Interpret epidemiological findings for evidence-based decision-making.
- Develop strategies for outbreak investigation and disease surveillance.
Infectious Disease Control and Prevention
- Understand transmission, prevention, and control of infectious diseases.
- Implement vaccination and community health programs.
- Monitor and evaluate infection control interventions.
- Analyze epidemiological data to inform public health policies.
- Apply global health strategies to reduce infectious disease burden.
Non-Communicable Diseases and Chronic Care Management
- Assess population-level risk factors for non-communicable diseases.
- Design prevention and management programs for chronic illnesses.
- Implement community-based interventions to improve long-term health outcomes.
- Analyze health trends to inform public health strategies.
- Integrate lifestyle, nutrition, and behavioral approaches into chronic care.
Global Health Issues and Health Systems
- Evaluate global health challenges, trends, and disparities.
- Analyze international health systems and policy frameworks.
- Apply knowledge of global health governance to program planning.
- Develop strategies to improve access to care and equity in health outcomes.
- Integrate global perspectives in public health interventions.
Health Economics and Policy Implementation
- Understand economic principles applied to healthcare and public health.
- Evaluate cost-effectiveness of health programs and interventions.
- Apply policy analysis to design and implement health strategies.
- Integrate economic evaluation in resource allocation decisions.
- Promote sustainable and evidence-based health policy development.
Public Health Surveillance and Monitoring
- Design and implement public health surveillance systems.
- Monitor disease trends and population health indicators.
- Analyze surveillance data to detect outbreaks and health threats.
- Apply monitoring tools to evaluate public health program effectiveness.
- Develop strategies to strengthen data-driven decision-making.
Occupational and Environmental Health
- Assess workplace and environmental hazards affecting health.
- Implement strategies for occupational disease prevention.
- Apply regulatory frameworks and safety standards.
- Evaluate interventions to improve worker and community health.
- Promote sustainable practices to reduce environmental risks.
Community Health Assessment and Planning
- Conduct comprehensive community health needs assessments.
- Analyze demographic, epidemiological, and social data for planning.
- Develop evidence-based interventions tailored to community needs.
- Engage stakeholders in health program design and implementation.
- Monitor and evaluate community health outcomes.
Health Informatics and Digital Health Systems
- Apply digital tools to collect, manage, and analyze health data.
- Integrate health information systems into public health practice.
- Ensure data security, accuracy, and compliance with regulations.
- Use informatics to support decision-making and policy planning.
- Develop skills in electronic health records, telemedicine, and digital monitoring.
Programme Evaluation and Impact Assessment
- Design evaluation frameworks for public health interventions.
- Measure program effectiveness and impact on population health.
- Apply qualitative and quantitative evaluation methods.
- Develop recommendations to improve health programs.
- Use evaluation findings for continuous quality improvement.
Leadership and Teamwork in Public Health
- Develop leadership skills for managing public health projects.
- Foster collaboration within multidisciplinary health teams.
- Implement effective communication and decision-making strategies.
- Promote professional ethics and accountability.
- Enhance capacity to lead complex health interventions.
Applied Research Methods in Epidemiology
- Conduct advanced research studies in public health and epidemiology.
- Apply rigorous research methodologies to population health questions.
- Analyze and interpret complex epidemiological data.
- Develop evidence-based recommendations for interventions.
- Publish or present research findings in professional contexts.
Year 3: Advanced Specialisation and Professional Application
Advanced Public Health Interventions
- Design and implement large-scale public health programs.
- Apply evidence-based strategies to prevent disease and improve health outcomes.
- Evaluate program efficiency and effectiveness using advanced metrics.
- Develop interventions tailored to diverse populations.
- Integrate global and local health priorities into intervention planning.
Clinical Epidemiology and Evidence-Based Practice
- Apply epidemiological methods to clinical and public health practice.
- Interpret clinical and population-level data for informed decision-making.
- Integrate evidence-based approaches in health policy and interventions.
- Evaluate clinical outcomes to improve patient and community health.
- Develop skills for translating research into practice.
Health Risk Assessment and Management
- Identify, assess, and manage public health risks in communities.
- Apply risk communication strategies to stakeholders.
- Evaluate environmental, occupational, and lifestyle-related hazards.
- Develop mitigation plans to minimize adverse health outcomes.
- Integrate risk management frameworks into health policy and planning.
Biostatistics for Advanced Research
- Apply advanced statistical methods in epidemiological research.
- Use software tools for complex data analysis.
- Interpret results for public health decision-making.
- Develop predictive models for health outcomes and interventions.
- Support research, surveillance, and policy planning with quantitative evidence.
Global Health Policy and Strategy Development
- Formulate policies addressing global health challenges.
- Analyze international health systems and governance structures.
- Develop strategic plans for disease prevention and health promotion.
- Integrate evidence-based research into policy design.
- Promote global equity and sustainable health outcomes.
Emergency Preparedness and Disaster Management
- Plan and implement public health emergency response strategies.
- Analyze risks from natural disasters, epidemics, and humanitarian crises.
- Coordinate community and health system preparedness programs.
- Apply epidemiological and logistical methods in emergency management.
- Develop skills to mitigate health impacts during crises.
Maternal and Child Health Epidemiology
- Analyze health issues affecting mothers, infants, and children.
- Design interventions to improve maternal and child health outcomes.
- Apply surveillance and research methods in maternal and child populations.
- Evaluate program effectiveness and policy impact.
- Integrate nutrition, immunization, and preventive care strategies.
Advanced Communicable Disease Control
- Implement evidence-based strategies for infectious disease prevention.
- Analyze outbreak trends and develop containment plans.
- Apply vaccination, surveillance, and diagnostic methods effectively.
- Develop multi-sectoral approaches for disease control.
- Evaluate public health interventions and recommend improvements.
Health Communication and Advocacy
- Develop effective communication strategies for health promotion.
- Engage communities and stakeholders to advocate for policy changes.
- Utilize digital platforms for public health messaging.
- Apply behavioral change theories in communication campaigns.
- Measure impact of advocacy efforts on health outcomes.
Quality Improvement and Risk Management in Healthcare
- Apply quality management principles in health systems.
- Conduct risk assessments to ensure safe and effective service delivery.
- Develop strategies to improve clinical and public health practices.
- Evaluate health programs for continuous improvement.
- Integrate evidence-based standards to enhance healthcare quality.
Capstone Research Project / Dissertation
- Conduct independent research addressing real world public health problems.
- Apply epidemiological methods and biostatistical analysis.
- Develop evidence-based recommendations for policy or practice.
- Present findings in professional or academic formats.
- Demonstrate comprehensive mastery of public health and epidemiology.
Professional Practice and Field Placement
- Gain hands-on experience in healthcare, community, or research settings.
- Apply theoretical knowledge in real-world public health projects.
- Develop practical skills in surveillance, data collection, and program implementation.
- Engage with multidisciplinary teams to address public health challenges.
- Demonstrate professionalism, ethical conduct, and competency in fieldwork.
The ICTQual AB Level 6 International Diploma in Public Health and Epidemiology is designed for individuals seeking to advance their careers in public health, healthcare management, epidemiology, and research. This course equips learners with the skills and knowledge to design, implement, and evaluate health programs, influence health policy, and improve population health outcomes globally.
1. Recent Graduates in Health Sciences
- Students with degrees in medicine, nursing, or allied health fields.
- Individuals aiming for advanced knowledge in public health and epidemiology.
- Learners seeking a globally recognized Level 6 diploma.
- Candidates interested in research, data analysis, and health program planning.
- Graduates aiming to enhance employability in healthcare or policy sectors.
2. Healthcare Professionals and Practitioners
- Doctors, nurses, and allied health workers looking to specialize in public health.
- Professionals aiming to lead community health initiatives and disease prevention programs.
- Practitioners interested in outbreak investigation and health surveillance.
- Individuals seeking international recognition to progress in healthcare leadership roles.
- Professionals wanting to improve skills in evidence-based decision-making.
3. Aspiring Public Health and Epidemiology Researchers
- Individuals pursuing research careers in population health and epidemiology.
- Learners seeking expertise in study design, biostatistics, and advanced research methods.
- Candidates aiming to publish or present research findings in professional forums.
- Professionals interested in global health policy and strategy development.
- Researchers looking to apply data-driven approaches to solve public health challenges.
4. Policy Makers and Health Administrators
- Government and NGO employees involved in health program planning and evaluation.
- Individuals responsible for designing and implementing public health policies.
- Professionals aiming to enhance leadership and management in healthcare systems.
- Candidates seeking skills to assess program impact and optimize resource allocation.
- Administrators looking to strengthen health systems at local and global levels.
5. Career Changers into Public Health
- Professionals from related fields wanting to transition into public health and epidemiology.
- Individuals seeking internationally recognized credentials to boost credibility.
- Learners aiming to develop practical skills in health assessment, planning, and evaluation.
- Candidates interested in flexible online learning with global relevance.
- Professionals wanting to expand career opportunities in healthcare and research.
6. International Students Seeking Global Careers
- Students aiming to earn a globally recognized public health diploma.
- Individuals looking to work in international health organizations, NGOs, or research institutes.
- Learners wanting exposure to global health policies and emerging health trends.
- Candidates interested in flexible, online, and practice-oriented learning.
- Students seeking career growth in public health, epidemiology, or healthcare leadership.
7. Community Health Advocates and Program Managers
- Individuals responsible for community health initiatives and outreach programs.
- Professionals aiming to design and implement disease prevention and health promotion campaigns.
- Learners seeking advanced knowledge in epidemiology, surveillance, and program evaluation.
- Candidates wanting to measure and improve community health outcomes.
- Professionals striving to make a tangible impact on public health at local and global levels.
Register Now
Related Qualifications

ProQual Level 3 NVQ Certificate in Occupational Health and Safety

ProQual Level 7 Diploma in Occupational Health and Safety Management

ProQual Level 3 Certificate in Assessing Vocational Achievement